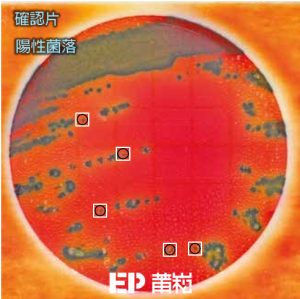

- 用於檢測食品檢體和食品加工環境檢體中是否有沙門氏菌的存在
- 定性方法
- 44小時內產生結果
- 只需3個簡單的步驟,即可快速得到準確結果
- 提供一致、可靠的測試結果
- 提供備妥樣品的培養基系統,可省略製備培養基/培養皿等耗時、麻煩的步驟
- 已獲得公定分析法官方方法(AOAC-OMA)認可:#2014.01
- 已獲得AOAC-PTM分析法認可:#061301
- 相較於傳統培養皿檢測方法,3M™ Petrifilm™ 快檢片減少了75%的能源使用、79%的水源使用、75%的溫室氣體產生、以及66%的廢棄物產生(以重量和體積估計)
- 國際間各企業信任3M™ Petrifilm™ 快檢片的檢測結果,可得到準確、有效、一致的結果
- 定性偵測極限(LOD):各樣品1-5 CFU沙門氏菌(每25g樣品)
增殖培養基:
成分❶:3M™ Salmonella Enrichment Base #SEB500 (500 g/罐)
成分❷:3M™ Salmonella Enrichment Supplement #SESUP001 (1 g/罐)
增殖培養基製備:
→ 取37g成分❶,溶於1 L純水中。混勻後滅菌15分鐘@121°C。
→ 滅菌後取出,待降溫至20-42.5°C後,加入50mg成分❷。
→ 待溶解後混勻即完成。
<第一階段>
☞當<第一階段>中發現疑似菌落,才須進入<第二階段>,從所有的疑似菌落(非紅紫色)中鑑定出確切的沙門氏菌。疑似菌落情形請見下表:
| 菌落顏色 | 代謝特性 | 結果 | |||
|---|---|---|---|---|---|
| 紅色 | 深紅色 | 棕色 | 底色變黃 | 氣泡產生 | |
| ✓ | ✓ | 疑似菌落 | |||
| ✓ | ✓ | 疑似菌落 | |||
| ✓ | ✓ | ✓ | 疑似菌落 | ||
| ✓ | ✓ | 疑似菌落 | |||
| ✓ | ✓ | 疑似菌落 | |||
| ✓ | ✓ | ✓ | 疑似菌落 | ||
| ✓ | ✓ | 疑似菌落 | |||
| ✓ | ✓ | 疑似菌落 | |||
| ✓ | ✓ | ✓ | 疑似菌落 | ||
<第二階段>
用3M™ Petrifilm™ 沙門氏菌確認片(6538),於高背景菌落。從疑似菌落中鑑定出沙門氏菌菌落。
☞沙門氏菌菌落於<第二階段>沙門氏菌確認片反應下呈現兩種典型狀況:
❶菌落呈現深藍至黑色(左)。
❷菌落中心呈紅色,周圍為深藍至黑色(右)。

☞ 實際判讀範例:請移動滑鼠至下列圖例
範 例 ①


範 例 ②

- 規格、操作條件 & 使用限制:
0
每包片數(片)
0
培養堆疊片數上限(片)
0
定性檢測極限1-5 CFU
0
前增殖時間18-24小時
0
培養溫度±1℃
0
快檢片培養時間±2小時
0
確認片反應時間4-5小時
3M™ Petrifilm™ 快檢片的優勢:
在現今的環境中,食品安全越來越受重視,品質要求日益嚴格,實驗室面臨著壓力,必須提供快速、可靠和一致準確的測試。3M™ Petrifilm™ 快檢片已證明了具有穩定的性能,擁有200多項認證、評鑑、核准且歷經同業審查。30多年來,世界各地的食品安全專業人員都將信任託付於3M™ Petrifilm™ 快檢片,因為3M™ Petrifilm™ 快檢片以效率化、標準化和簡化微生物質量指示劑測試的過程,提高生產力,並確保優質的產品品質。
產品資源 RESOURCES
手冊 BROCHURES
- 3M Pathogen and Toxin Testing (PDF, 440.0KB)
- 3M Petrifilm Salmonella Express Plate Presumptive Positive Salmonella Colors (PDF, 79.8KB)
- 3M Petrifilm Salmonella Express System Launch Kit Insert (PDF, 630.2KB)
- 3M™ Petrifilm™ Salmonella Express System (PDF, 2.6MB)
- 沙門氏菌中文操作說明及判讀手冊 (PDF)
發布消息 BULETIN
- 3M Petrifilm Salmonella Express System – Silver Edison Award (PDF, 25.9KB)
- 3M Petrifilm Salmonella Express System (PDF, 48.3KB)
案例研究 CASE STUDIES
- 3M Petrifilm Plates Sustainability White Paper (PDF, 143.0KB)
- 3M Petrifilm Salmonella Express System Q Labs Study (PDF, 981.9KB)
- 3M Petrifilm Salmonella Express System in Food & Environmental Surfaces Study (PDF, 284.7KB)
簡介 FLYERS
- 3M Petrifilm Salmonella Express Starter Package Promotion (PDF, 200.2KB)
- 3M Petrifilm Salmonella Express System (PDF, 576.9KB)
操作說明 INSTRUCTIONS
- Product Instructions: 3M™ Petrifilm™ Salmonella Express System (PDF, 636.9KB)
- SALX 70-2009-9517-6_Rev-1217 LR (PDF, 771.5KB)
物質安全資料表 SDS
認證一覽表 REGULATORY MATERIALS
產品影片 PRODUCT VIDEOS
